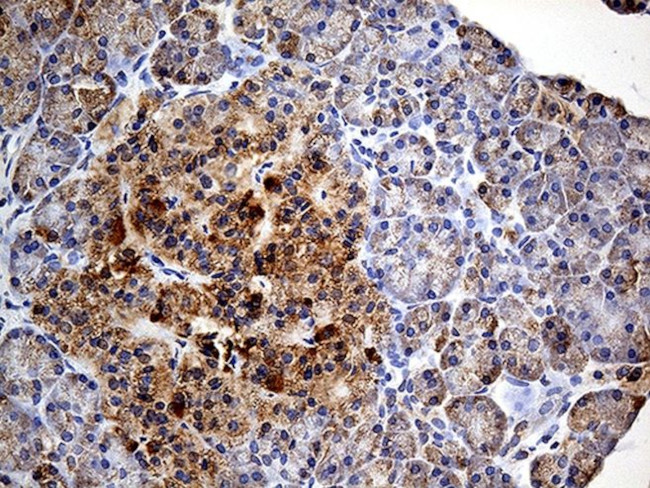
COX17 Antibody in Immunohistochemistry (Paraffin) (IHC (P))
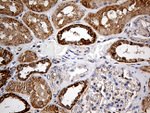
COX17 Antibody in Immunohistochemistry (Paraffin) (IHC (P))

Search
OriGene
COX17 Monoclonal Antibody (OTI2D7), TrueMAB™
{{$productOrderCtrl.translations['antibody.pdp.commerceCard.promotion.promotions']}}
{{$productOrderCtrl.translations['antibody.pdp.commerceCard.promotion.viewpromo']}}
{{$productOrderCtrl.translations['antibody.pdp.commerceCard.promotion.promocode']}}: {{promo.promoCode}} {{promo.promoTitle}} {{promo.promoDescription}}. {{$productOrderCtrl.translations['antibody.pdp.commerceCard.promotion.learnmore']}}
产品信息
TA812118
种属反应
宿主/亚型
分类
类型
克隆号
抗原
偶联物
形式
浓度
规格
纯化类型
保存液
内含物
保存条件
运输条件
靶标信息
Cytochrome c oxidase 17 (COX17) is a nuclear gene encoding an assembly protein necessary for proper COX apoenzyme-dependent mitochondrial respiration. The mammalian COX apoenzyme is a heteromer consisting of three mitochondrial genes that encode catalytic subunits and several nuclear genes that encode structural subunits. COX17 influences the recruitment of copper to the mitochondria for incorporation into the COX apoenzyme.
仅用于科研。不用于诊断过程。未经明确授权不得转售。
篇参考文献 (0)
生物信息学
蛋白别名: COX17 cytochrome c oxidase assembly homolog; COX17, cytochrome c oxidase copper chaperone; cytochrome c oxidase 17 copper chaperone; cytochrome c oxidase assembly homolog 17; Cytochrome c oxidase copper chaperone; human homolog of yeast mitochondrial copper recruitment; unnamed protein product
基因别名: COX17
UniProt ID: (Human) Q14061
Entrez Gene ID: (Human) 10063